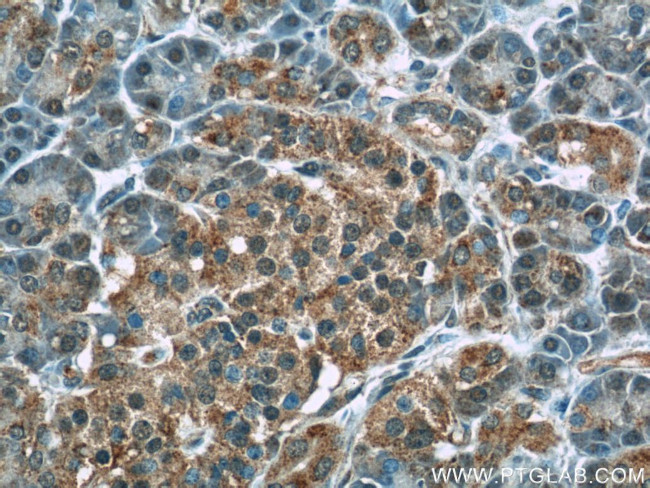
WFDC3 Antibody in Immunohistochemistry (Paraffin) (IHC (P))

Search
Proteintech
WFDC3 Polyclonal Antibody
{{$productOrderCtrl.translations['antibody.pdp.commerceCard.promotion.promotions']}}
{{$productOrderCtrl.translations['antibody.pdp.commerceCard.promotion.viewpromo']}}
{{$productOrderCtrl.translations['antibody.pdp.commerceCard.promotion.promocode']}}: {{promo.promoCode}} {{promo.promoTitle}} {{promo.promoDescription}}. {{$productOrderCtrl.translations['antibody.pdp.commerceCard.promotion.learnmore']}}
产品信息
24917-1-AP
种属反应
宿主/亚型
分类
类型
抗原
偶联物
形式
浓度
规格
纯化类型
保存液
内含物
保存条件
运输条件
产品详细信息
Immunogen sequence: GEHAKEGEC PPHKNPCKEL CQGDELCPAE QKCCTTGCGR ICRDIPKGRK RDCPRVIRKQ SCLKRCITDE TCPGVKKCCT LGCNKSCVVP ISKQKLAEFG GECPADPLPC EELCDGDASC PQGHKCCSTG CGRTCLGDIE GGRGGDCPKV LVGLCIVGCV MDENCQAGEK CCKSGCGRFC VPPVLPPKLT MNPNWTVRSD SELEIPVP (25-231 aa encoded by BC148860 )
靶标信息
This gene encodes a member of the WAP-type four-disulfide core (WFDC) domain family. The WFDC domain, or WAP signature motif, contains eight cysteines forming four disulfide bonds at the core of the protein, and functions as a protease inhibitor. The encoded protein contains four WFDC domains. Most WFDC genes are localized to chromosome 20q12-q13 in two clusters: centromeric and telomeric. This gene belongs to the telomeric cluster. Alternatively spliced transcript variants have been observed but their full-length nature has not been determined.
仅用于科研。不用于诊断过程。未经明确授权不得转售。
篇参考文献 (0)
生物信息学
蛋白别名: protease inhibitor WAP14; Putative protease inhibitor WAP14; WAP four-disulfide core domain protein 3; whey acidic protein 14
基因别名: dJ447F3.3; WAP14; WFDC3
UniProt ID: (Human) Q8IUB2
Entrez Gene ID: (Human) 140686